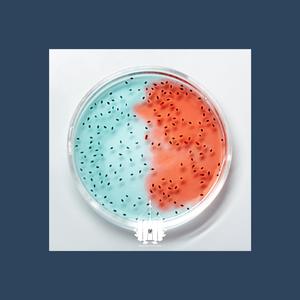
舔狗日记

舔狗日记
Vic梁子锋, 田乐Abeles

舔狗日记
Lolodean, 火山

为什么不回消息
xxxmiracle, 廖峻贤

舔狗
连麻Swimming

舔狗相对论
徐17

舔狗帮
暴躁的兔子

HADE-歌曲异常(查无此人 remix)
查无此人

舔狗日记
6小7

舔狗日记
兰益

备胎日记
Bo Peep

舔狗日记1.0
焦焦今天睡饱了么

舔狗日记(best dog)
宇宙末班车

我会变成你的谁 Prod by Redkiller
H.circle

舔狗日记:渣女篇
卡了佛度colorfuldo

舔狗日记 Prod.Gr33nart Beats
Rstuv

舔狗日记
MarcoLius, $usney

舔狗日记(Prod.curtains)
杨继森, Louis 1520

舔狗日记
铁皮青蛙乐队

"舔狗日记"
SevenjBeatZ

舔狗日记 (prod.Gr33nart Beats)
吃饭没有菜
舔狗日记
WayMen, CharonLai莱宝一, Kumark漱一

舔狗日记
查无此人

一见钟情·书(Prod_24.t)
Cozy G

舔狗日记
山岛

舔狗日记(prod.by zaddi)
FB1xxx

舔狗日记
元初

舔狗日记
刘兆宇, 陈奕楠

舔狗之歌
张振Cee

舔狗日记
曲调同学

舔狗日记
xXxYoun9_